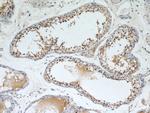
SEPT9 Antibody in Immunohistochemistry (Paraffin) (IHC (P))

Search
Proteintech
SEPT9 Polyclonal Antibody
{{$productOrderCtrl.translations['antibody.pdp.commerceCard.promotion.promotions']}}
{{$productOrderCtrl.translations['antibody.pdp.commerceCard.promotion.viewpromo']}}
{{$productOrderCtrl.translations['antibody.pdp.commerceCard.promotion.promocode']}}: {{promo.promoCode}} {{promo.promoTitle}} {{promo.promoDescription}}. {{$productOrderCtrl.translations['antibody.pdp.commerceCard.promotion.learnmore']}}
产品信息
10769-1-AP
种属反应
已发表种属
宿主/亚型
分类
类型
抗原
偶联物
形式
浓度
规格
纯化类型
保存液
内含物
保存条件
运输条件
产品详细信息
Immunogen sequence: RNEKAPVDF GYVGIDSILE QMRRKAMKQG FEFNIMVVGQ SGLGKSTLIN TLFKSKISRK SVQPTSEERI PKTIEIKSIT HDIEEKGVRM KLTVIDTPGF GDHINNENCW QPIMKFINDQ YEKYLQEEVN INRKKRIPDT RVHCCLYFIP ATGHSLRPLD IEFMKRLSKV VNIVPVIAKA DTLTLEERVH FKQRITADLL SNGIDVYPQK EFDEDSEDRL VNEKFREMIP FAVVGSDHEY QVNGKRILGR KTKWGTIEVE NTTHCEFAYL RDLLIRTHMQ NIKDITSSIH FEAYRVKRLN EGSSAMANGV EEKEPEAPEM (250-568 aa encoded by BC021192)
靶标信息
The maf oncogene was identified by structural analysis of the AS42 avian transforming retrovirus genome. The Maf family is divided into two subclasses, large Mafs (vMaf, cMaf, MafB and Nrl) and small Mafs (MafF, MafK, and MafG). Both subclasses contain leucinezipper motifs, which allow homodimerization as well as heterodimerization with a variety of other bZip transcription factors. Large Mafs also contain an acidic transactivation domain absent in the small Maf proteins. Although they do not possess inherent transactivation activity, small Maf proteins can act as positive regulators of transcription by targeting transcriptionally active dimerization partners to specific DNA regulatory elements. Conversely, small Mafs can act also as negative regulators of transcription by recruiting transcriptional repressors or by forming homodimers that can replace active dimers. Human MafF was isolated in a yeast one-hybrid system from a human myometrium cDNA library. Human MAFF encodes a 164 amino acids proten. Like other small MAFF proteins, it contains an extended leucine zipper structure and lacks an N-terminal transactivating domain. The three small Maf proteins have been implicated in a number of physiological processes, including development, differentiation, haematopoiesis and stress response. Interestingly, these three proteins regulate the stress response via different mechanisms.
仅用于科研。不用于诊断过程。未经明确授权不得转售。
生物信息学
蛋白别名: E-septin; Eighth septin; Eseptin; MLL septin-like fusion; MLL septin-like fusion protein; MLL septin-like fusion protein MSF-A; Ov/Br septin; Ovarian/Breast septin; peanut-like 4; Septin D1; Septin-9; Septin-like protein; SL3-3 integration site 1 protein; SLP; unnamed protein product
基因别名: AF17q25; Eseptin; KIAA0991; MSF; MSF1; NAPB; PNUTL4; SEPT9; SeptD1; SEPTIN9; SINT1; Slpa
UniProt ID: (Human) Q9UHD8, (Rat) Q9QZR6, (Mouse) Q80UG5
Entrez Gene ID: (Human) 10801, (Rat) 83788, (Mouse) 53860